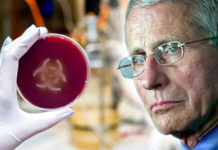

Svjetska Zdravstvena Organizacija puč priprema
Svjestska Zdravstvena Organizacija- preuzimanje moći događa se SADA – naše slobode su u opasnosti.
Sljedeći tjedan neizabrane globalne elite sastaju se u Ženevi kako bi
progurale...
Velikosrpski dernek u Sjevernoj Makedoniji
U središtu Skoplja Dodika održao govor protiv EU i protiv NATO-a
Milorada Dodika, koji je bio jedan od gostiju proslave srpskog blagdana Svetog Save. Taj...
Mirna reintegracija hrvatskog Podunavlja
U organizaciji Zajednice povratnika Osječko-baranjske županije jučer je tribinom »Mirna reintegracija hrvatskog Podunavlja 15. siječnja 1996. – 15. siječnja 1998.« obilježena 27. godišnjica završetka...
CIA EKSPERIMENT 1956. godine: Raspršivanje kemikalija u obliku aerosola kroz ispušne cijevi automobila i...
Isti su znanstvenici potvrdili kako se, nakon eksperimenta Pont St. Esprit, Odjela za specijalne operacije Fort Detricka vratio se u New York 1956. godine...
GAZA – 1,4 trilijuna kubičnih metara prirodnog plina +18 bilijuna kubičnih metara plina, dio...
Godine 2007., godinu dana prije akcije "Lijevanog olova", pozornost Moshe Yaalona, ministra obrane i bivšeg načelnika stožera, usredotočila se na 1,4 trilijuna kubičnih metara...
PRVI KRUG PREDSJEDNIČKIH IZBORA JE OPET NEREGULARAN
PRVI KRUG PREDSJEDNIČKIH IZBORA JE OPET NEREGULARAN ZBOG BIRAČA S FIKTIVNIM PREBIVALIŠTEM U HRVATSKOJ mr. sc Edo Zenzerović, dipl. ing. elektr.
Na izborima za predsjednika...
Robert F. Kennedy praktički proglasio Faucija gorim od J. Mengelea!
Robert F. Kennedy otkriva kako je Fauci, glavni američki " stožeraš" iz lažne pandemije covida eksperimentirao, mučio i ubijao nevinu siročad koja nisu imala...
KAKO POVEČATI SIGURNOST U ŠKOLAMA ?!
KAKO POVEČATI SIGURNOST U ŠKOLAMA
Tragedija koja se dogodila u Zagrebu u Osnovnoj školi Prečko duboko nas je sve potresla. Izgubljen je jedan mladi život,...
UN plan novog svjetskog poretka baziran na komunizmu ili fašizmu?
Plan Ujedinjenih naroda
Anna Von Reitz
Pokušavali smo izvući ključne točke stalno mijenjajućeg, pojavljivajućeg i nestajajućeg Programa Ujedinjenih naroda za "Novi Svjetski Poredak", koji nam se...
Velislav Iliev: Vlast u S. Makedoniji šuti o mučenju bugarskih studenata u Skoplju 1927....
Velislav Iliev: Režim u S. Makedoniji šutio o mučenju bugarskih studenata u Skoplju 1927. godine od strane Srba
Otkako ste preuzeli vlast u sjevernoj Makedoniji,...